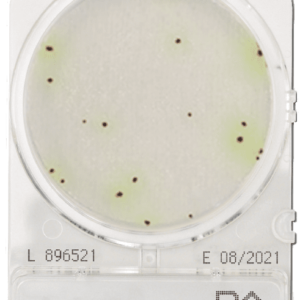
CompactDry PA
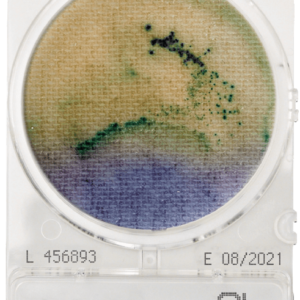
CompactDry SL
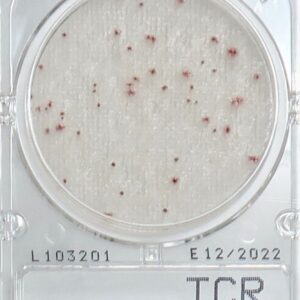
CompactDry TCR
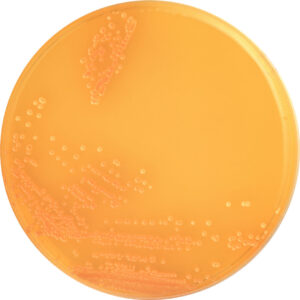
CW Agar Base without KM

Products
Showing 106–120 of 214 results
-
CompactDry PA
-
CompactDry SL
-
CompactDry TC
-
CompactDry TCR
-
CompactDry VP
-
CompactDry X-SA
-
CompactDry YM
-
CompactDry YMR
-
Cow milk adulteration in goat milk
-
Cow Milk Adulteration in Goat Milk and Sheep Milk
-
Cow Whey Adulteration in Milk
-
CW Agar Base without KM
-
Deoxynivalenol (DON) Quantitative Rapid Test Kitfor Cereals and Feed (200-8000 ppb)
-
Deoxynivalenol (DON) Rapid Test Kit for Cereals and Feed
-
DHL Agar